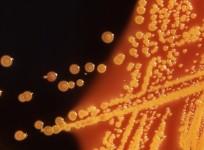

Science & Health


Chennai, Pune authorities reject public breastfeeding events to avoid 'skin shows'
Your nose contains an effective antibiotic that may prevent deadliest infections

Conjoined twins who share a heart present medical puzzle for Mumbai doctors

World Breastfeeding Week: Delaying breastfeeding in first few hours can lead to baby's death, says UNICEF

Late puberty, menopause may help women live longer

Doctors should replace branded medicines with generic ones to make medicines affordable, says Govt

Remove transgender identity from category of mental disorders, scientists tell WHO

Japanese Encephalitis claims 3 lives in Manipur, state on alert

Biocon launches 'Ek Prayaas' national awareness drive on Hepatitis C

24 surgeries in 24 hours: Mumbai ophthalmologist infuses hopes in Kashmir's pellet victims
Indian-origin gynaecologist gets 8 years in prison for sexually abusing his patients

World Hepatitis Day: Hepatitis a silent killer in India, claims one lakh lives every year

If you are suffering from type-2 diabetes, it's time to get vaccinated

Iraqi boy dies after 'anaesthetic overdose' in Gurgaon clinic
Advertisement
Advertisement